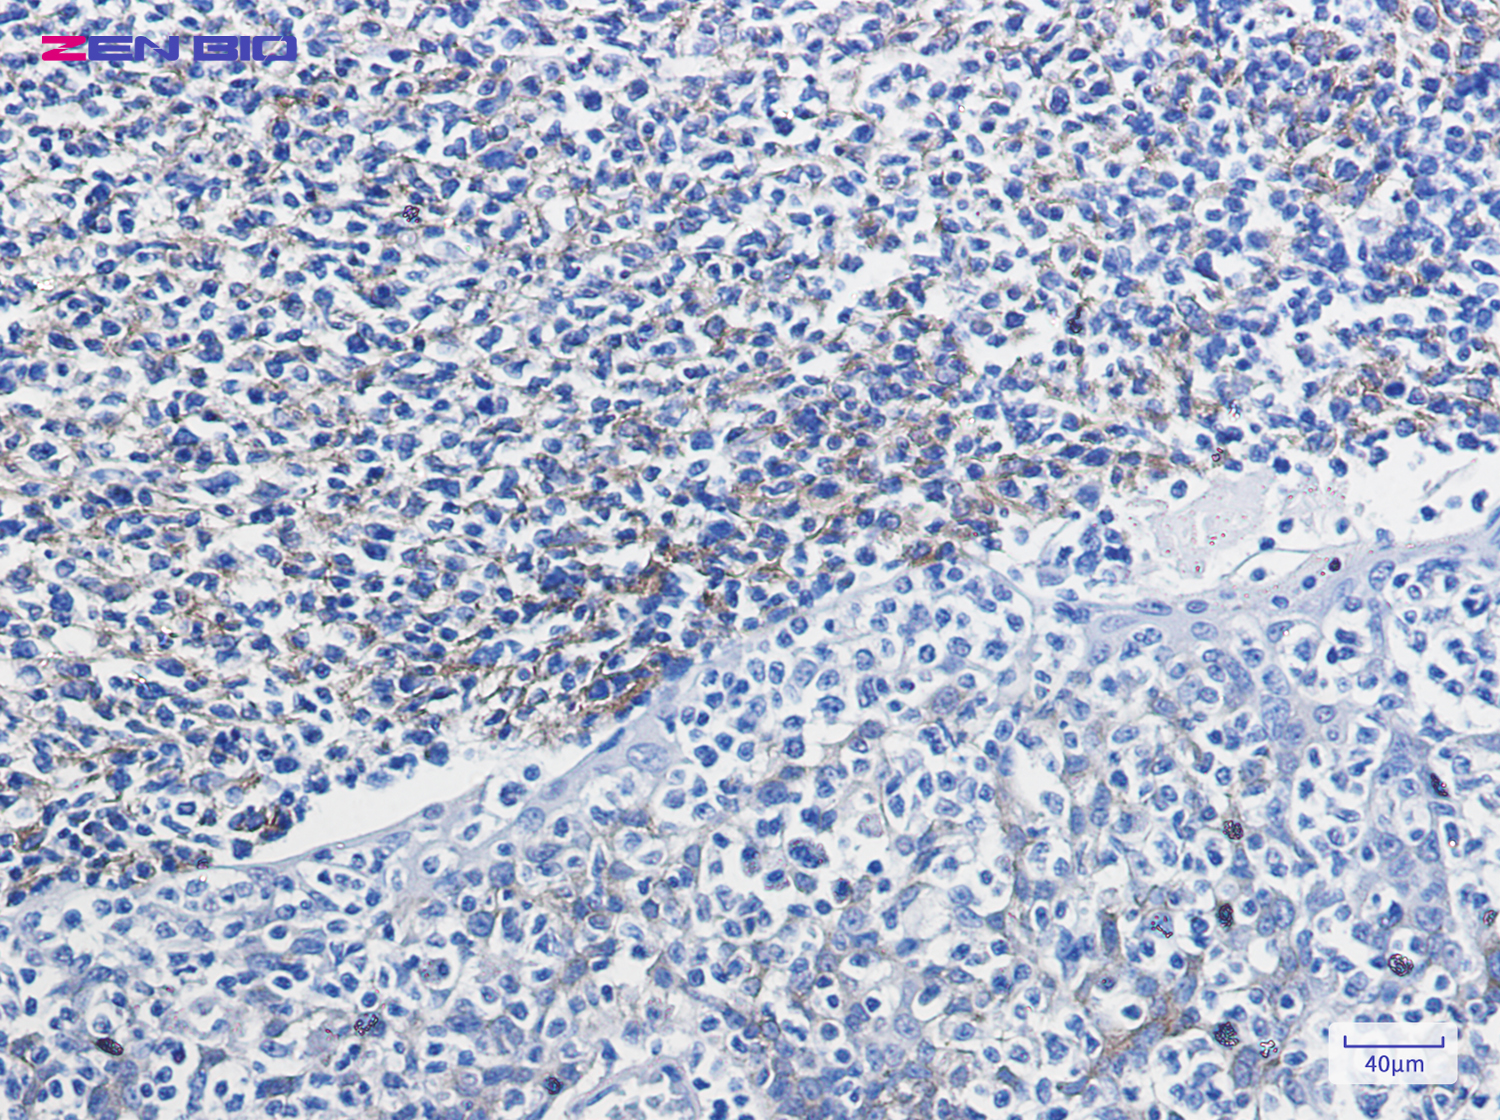
Immunohistochemistry of VCAM1 in paraffin-embedded Human tonsil using VCAM1 Rabbit pAb at dilution 1/100

-
Product Name
Anti-VCAM1 Rabbit antibody
- Documents
-
Description
VCAM1 Rabbit polyclonal antibody
-
Tested applications
WB, IHC-P, ICC/IF, FC, IP
-
Species reactivity
Human, Mouse, Rat
-
Isotype
Rabbit IgG
-
Preparation
Antigen: A synthetic peptide of mouse VCAM1
-
Clonality
Polyclonal
-
Formulation
Supplied in 50nM Tris-Glycine(pH 7.4), 0.15M Nacl, 40%Glycerol, 0.01% sodium azide and 0.05% BSA.
-
Storage instructions
Store at -20°C. Stable for 12 months from date of receipt.
-
Applications
WB: 1/2000
IHC: 1/20-1/500
ICC/IF: 1/50
FC: 1/20
IP: 1/20
-
Validations
Immunohistochemistry of VCAM1 in paraffin-embedded Human tonsil using VCAM1 Rabbit pAb at dilution 1/100

Western blot detection of VCAM1 in 3T3 cell lysates using VCAM1 Rabbit pAb(1:1000 diluted).Predicted band size:81KDa.Observed band size:110KDa.
-
Background
Swiss-Prot Acc.P19320.Important in cell-cell recognition. Appears to function in leukocyte-endothelial cell adhesion. Interacts with integrin alpha-4/beta-1 (ITGA4/ITGB1) on leukocytes, and mediates both adhesion and signal transduction. The VCAM1/ITGA4/ITGB1 interaction may play a pathophysiologic role both in immune responses and in leukocyte emigration to sites of inflammation.
Related Products / Services
Please note: All products are "FOR RESEARCH USE ONLY AND ARE NOT INTENDED FOR DIAGNOSTIC OR THERAPEUTIC USE"
